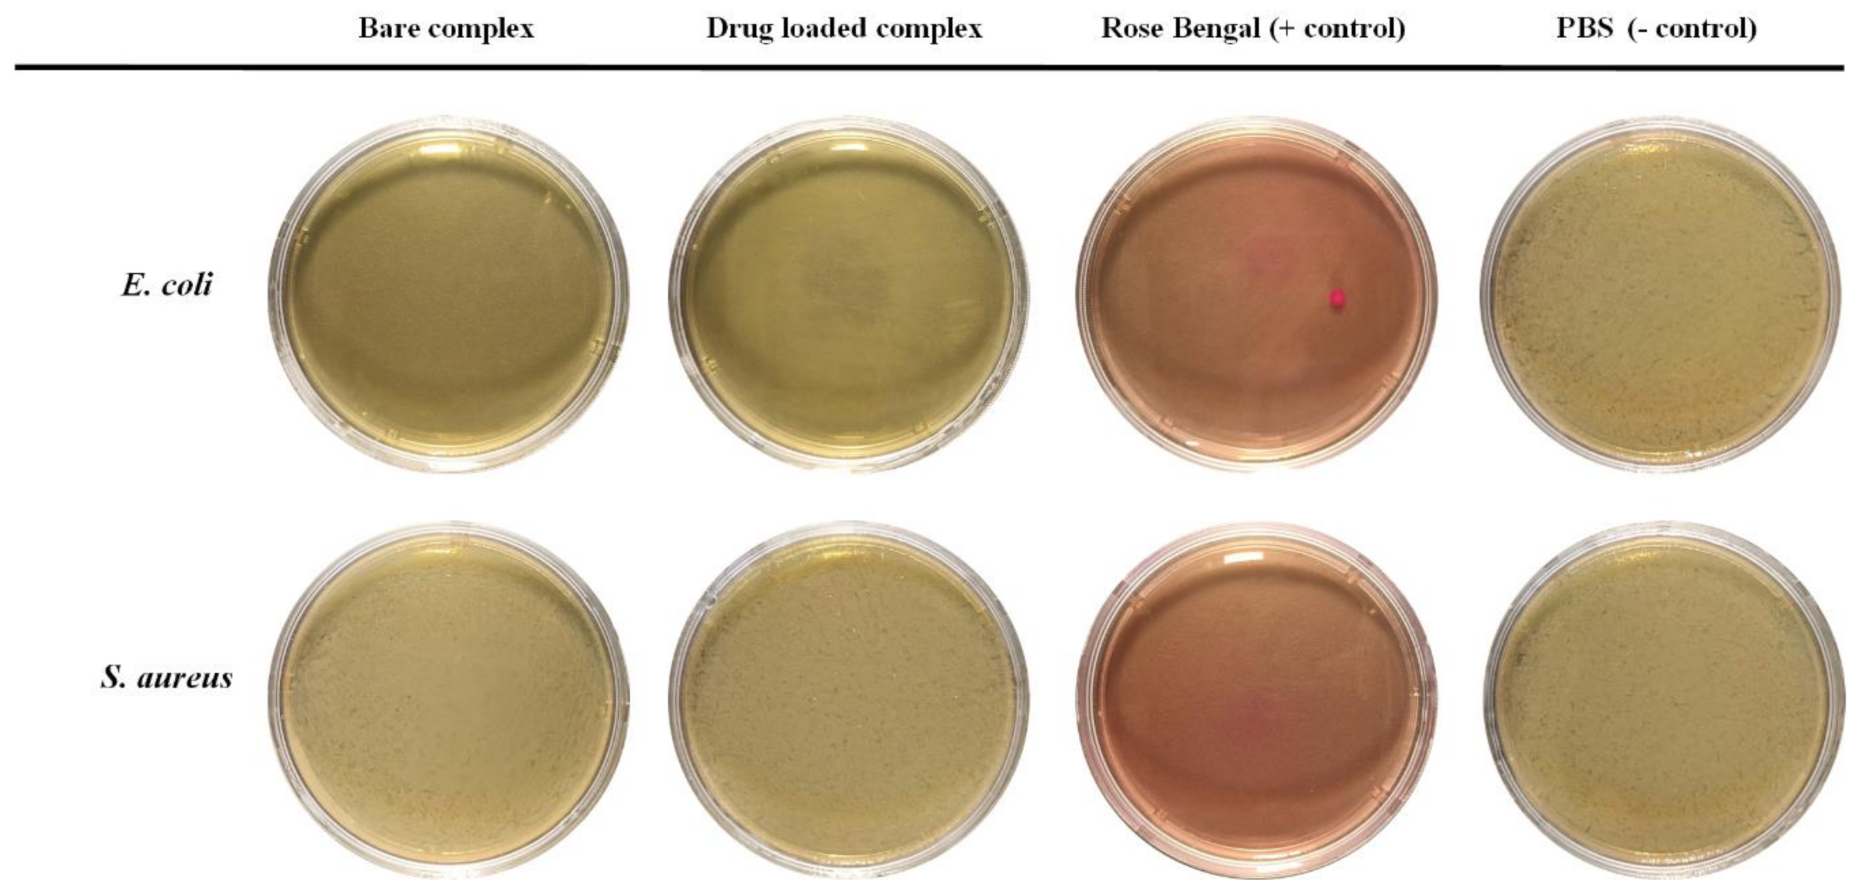
Polymers 15 00298 g006

Fabrication of a Dual-Drug-Loaded Smart Niosome-g-Chitosan Polymeric Platform for Lung Cancer Treatment
Abstract
1. Introduction
2. Materials and Methods
2.1. Materials
2.2. Preparation of Curcumin Loaded Niosomes
2.3. Preparation of Chitosan-Coated Niosome Nanoparticles
2.3.1. Grafted Polymer Fabrication
2.3.2. Fabrication of CSgPVCL-Coated Niosomes
2.4. Physicochemical Characterization
2.4.1. Size and Zeta Potential
2.4.2. Electron Microscopy
2.4.3. Fourier Transform Infrared (FTIR) Spectroscopy
2.5. Determination of Encapsulation Efficiency and Loading Capacity of the Nanoparticles
2.6. Drug Release Test and Release Kinetics Analysis
2.7. Cytotoxicity Assay
2.8. Antibacterial Test
2.9. Statistical Analysis
3. Results
3.1. Characterization of Nanoparticles
3.2. In Vitro Evaluation of Drug Loading and Released Pattern
3.3. Evaluation of Drug Release Kinetic
3.4. Anticancer Activity Test
3.5. Antibacterial Test
4. Discussion
5. Conclusions
Supplementary Materials
Author Contributions
Funding
Institutional Review Board Statement
Informed Consent Statement
Data Availability Statement
Conflicts of Interest
References
- Lee, R.; Choi, Y.J.; Jeong, M.S.; Park, Y.I.; Motoyama, K.; Kim, M.W.; Kwon, S.-H.; Choi, J.H. Hyaluronic acid-decorated glycol chitosan nanoparticles for pH-sensitive controlled release of doxorubicin and celecoxib in nonsmall cell lung cancer. Bioconjugate Chem. 2020, 31, 923–932. [Google Scholar] [CrossRef] [PubMed]
 - Saravanakumar, K.; Sathiyaseelan, A.; Mariadoss, A.V.A.; Jeevithan, E.; Hu, X.; Shin, S.; Wang, M.-H. Dual stimuli-responsive release of aptamer AS1411 decorated erlotinib loaded chitosan nanoparticles for non-small-cell lung carcinoma therapy. Carbohydr. Polym. 2020, 245, 116407. [Google Scholar] [CrossRef] [PubMed]
 - Zhang, L.; Wang, J.; Zhang, Y.; Ke, L.; Lin, X.; Li, Z.; Chen, H.; Gao, Y. Indocyanine green-encapsulated erlotinib modified chitosan nanoparticles for targeted chemo-photodynamic therapy of lung cancer cells. Dye. Pigment. 2019, 170, 107588. [Google Scholar] [CrossRef]
 - Almutairi, F.M.; Abd-Rabou, A.A.; Mohamed, M.S. Raloxifene-encapsulated hyaluronic acid-decorated chitosan nanoparticles selectively induce apoptosis in lung cancer cells. Bioorganic Med. Chem. 2019, 27, 1629–1638. [Google Scholar] [CrossRef] [PubMed]
 - Zhu, X.; Yu, Z.; Feng, L.; Deng, L.; Fang, Z.; Liu, Z.; Li, Y.; Wu, X.; Qin, L.; Guo, R. Chitosan-based nanoparticle co-delivery of docetaxel and curcumin ameliorates anti-tumor chemoimmunotherapy in lung cancer. Carbohydr. Polym. 2021, 268, 118237. [Google Scholar] [CrossRef]
 - Aparajay, P.; Dev, A. Functionalized niosomes as a smart delivery device in cancer and fungal infection. Eur. J. Pharm. Sci. 2022, 168, 106052. [Google Scholar] [CrossRef]
 - Takzare, A.; Ghafoor, D.D.; Siddiqi, A.F.; Ravali, S.; Shalbaf, M.; Bakhtiar, M. Trachyspermum copticum essential oil incorporated niosome for cancer treatment. J. Drug Deliv. Sci. Technol. 2019, 52, 818–824. [Google Scholar]
 - Hemati, M.; Haghiralsadat, F.; Yazdian, F.; Jafari, F.; Moradi, A.; Malekpour-Dehkordi, Z. Development and characterization of a novel cationic PEGylated niosome-encapsulated forms of doxorubicin, quercetin and siRNA for the treatment of cancer by using combination therapy. Artif. Cells Nanomed. Biotechnol. 2019, 47, 1295–1311. [Google Scholar] [CrossRef]
 - Witika, B.A.; Bassey, K.E.; Demana, P.H.; Siwe-Noundou, X.; Poka, M.S. Current Advances in Specialised Niosomal Drug Delivery: Manufacture, Characterization and Drug Delivery Applications. Int. J. Mol. Sci. 2022, 23, 9668. [Google Scholar] [CrossRef]
 - Kurniawan, A.; Gunawan, F.; Nugraha, A.T.; Ismadji, S.; Wang, M.-J. Biocompatibility and drug release behavior of curcumin conjugated gold nanoparticles from aminosilane-functionalized electrospun poly (N-vinyl-2-pyrrolidone) fibers. Int. J. Pharm. 2017, 516, 158–169. [Google Scholar] [CrossRef]
 - Kurniawan, A.; Muneekaew, S.; Hung, C.-W.; Chou, S.-H.; Wang, M.-J. Modulated transdermal delivery of nonsteroidal anti-inflammatory drug by macroporous poly (vinyl alcohol)-graphene oxide nanocomposite films. Int. J. Pharm. 2019, 566, 708–716. [Google Scholar] [CrossRef]
 - Mangindaan, D.; Chen, C.-T.; Wang, M.-J. Integrating sol–gel with cold plasmas modified porous polycaprolactone membranes for the drug-release of silver-sulfadiazine and ketoprofen. Appl. Surf. Sci. 2012, 262, 114–119. [Google Scholar] [CrossRef]
 - Karimifard, S.; Rezaei, N.; Jamshidifar, E.; Moradi Falah Langeroodi, S.; Abdihaji, M.; Mansouri, A.; Hosseini, M.; Ahmadkhani, N.; Rahmati, Z.; Heydari, M. pH-responsive chitosan-adorned niosome nanocarriers for co-delivery of drugs for breast cancer therapy. ACS Appl. Nano Mater. 2022, 5, 8811–8825. [Google Scholar] [CrossRef]
 - Jin, C.; Lagoudas, G.K.; Zhao, C.; Bullman, S.; Bhutkar, A.; Hu, B.; Ameh, S.; Sandel, D.; Liang, X.S.; Mazzilli, S. Commensal microbiota promote lung cancer development via γδ T cells. Cell 2019, 176, 998–1013.e1016. [Google Scholar] [CrossRef]
 - Kovaleva, O.V.; Romashin, D.; Zborovskaya, I.B.; Davydov, M.M.; Shogenov, M.S.; Gratchev, A. Human lung microbiome on the way to cancer. J. Immunol. Res. 2019, 2019. [Google Scholar] [CrossRef]
 - Kim, Y.; Park, S.; Lee, E.; Cerbo, R.; Lee, S.; Ryu, C.; Kim, G.; Kim, J.; Ha, Y. Antibacterial compounds from rose Bengal-sensitized photooxidation of β-caryophyllene. J. Food Sci. 2008, 73, C540–C545. [Google Scholar] [CrossRef]
 - Kurosu, M.; Mitachi, K.; Yang, J.; Pershing, E.V.; Horowitz, B.D.; Wachter, E.A.; Lacey III, J.W.; Ji, Y.; Rodrigues, D.J. Antibacterial Activity of Pharmaceutical-Grade Rose Bengal: An Application of a Synthetic Dye in Antibacterial Therapies. Molecules 2022, 27, 322. [Google Scholar] [CrossRef]
 - Li, Y.; Wang, J.; Yang, Y.; Shi, J.; Zhang, H.; Yao, X.; Chen, W.; Zhang, X. A rose bengal/graphene oxide/PVA hybrid hydrogel with enhanced mechanical properties and light-triggered antibacterial activity for wound treatment. Mater. Sci. Eng. C 2021, 118, 111447. [Google Scholar] [CrossRef]
 - Nakonechny, F.; Barel, M.; David, A.; Koretz, S.; Litvak, B.; Ragozin, E.; Etinger, A.; Livne, O.; Pinhasi, Y.; Gellerman, G. Dark antibacterial activity of rose Bengal. Int. J. Mol. Sci. 2019, 20, 3196. [Google Scholar] [CrossRef]
 - Shrestha, A.; Hamblin, M.R.; Kishen, A. Photoactivated rose bengal functionalized chitosan nanoparticles produce antibacterial/biofilm activity and stabilize dentin-collagen. Nanomed. Nanotechnol. Biol. Med. 2014, 10, 491–501. [Google Scholar] [CrossRef]
 - Babu, A.; Amreddy, N.; Muralidharan, R.; Pathuri, G.; Gali, H.; Chen, A.; Zhao, Y.D.; Munshi, A.; Ramesh, R. Chemodrug delivery using integrin-targeted PLGA-Chitosan nanoparticle for lung cancer therapy. Sci. Rep. 2017, 7, 1–17. [Google Scholar] [CrossRef] [PubMed]
 - Li, X.; Wang, J.; Cui, R.; Xu, D.; Zhu, L.; Li, Z.; Chen, H.; Gao, Y.; Jia, L. Hypoxia/pH dual-responsive nitroimidazole-modified chitosan/rose bengal derivative nanoparticles for enhanced photodynamic anticancer therapy. Dye. Pigment. 2020, 179, 108395. [Google Scholar] [CrossRef]
 - Rad, M.E.; Egil, A.C.; Ince, G.O.; Yuce, M.; Zarrabi, A.J.C.; Physicochemical, S.A.; Aspects, E. Optimization of curcumin loaded niosomes for drug delivery applications. Colloids Surf. A Physicochem. Eng. Asp. 2022, 654, 129921. [Google Scholar]
 - Duan, C.; Zhang, D.; Wang, F.; Zheng, D.; Jia, L.; Feng, F.; Liu, Y.; Wang, Y.; Tian, K.; Wang, F. Chitosan-g-poly (N-isopropylacrylamide) based nanogels for tumor extracellular targeting. Int. J. Pharm. 2011, 409, 252–259. [Google Scholar] [CrossRef] [PubMed]
 - Paknia, F.; Mohabatkar, H.; Ahmadi-Zeidabadi, M.; Zarrabi, A. The convergence of in silico approach and nanomedicine for efficient cancer treatment; in vitro investigations on curcumin loaded multifunctional graphene oxide nanocomposite structure. J. Drug Deliv. Sci. Technol. 2022, 71, 103302. [Google Scholar] [CrossRef]
 - Damiri, F.; Bachra, Y.; Bounacir, C.; Laaraibi, A.; Berrada, M. Synthesis and characterization of lyophilized chitosan-based hydrogels cross-linked with benzaldehyde for controlled drug release. J. Chem. 2020, 2020. [Google Scholar] [CrossRef]
 - Zarepour, A.; Zarrabi, A.; Larsen, K.L. Fabricating β-cyclodextrin based pH-responsive nanotheranostics as a programmable polymeric nanocapsule for simultaneous diagnosis and therapy. Int. J. Nanomed. 2019, 14, 7017. [Google Scholar] [CrossRef]
 - Cui, H.; Siva, S.; Lin, L. Ultrasound processed cuminaldehyde/2-hydroxypropyl-β-cyclodextrin inclusion complex: Preparation, characterization and antibacterial activity. Ultrason. Sonochem. 2019, 56, 84–93. [Google Scholar] [CrossRef]
 - Raval, N.; Maheshwari, R.; Kalyane, D.; Youngren-Ortiz, S.R.; Chougule, M.B.; Tekade, R.K. Importance of physicochemical characterization of nanoparticles in pharmaceutical product development. In Basic Fundamentals of Drug Delivery; Rakesh, K.T., Ed.; Elsevier: Amsterdam, The Netherlands, 2019; pp. 369–400. [Google Scholar]
 - Egil, A.C.; Carmignani, A.; Battaglini, M.; Sengul, B.S.; Acar, E.; Ciofani, G.; Ince, G.O. Dual stimuli-responsive nanocarriers via a facile batch emulsion method for controlled release of Rose Bengal. J. Drug Deliv. Sci. Technol. 2022, 74, 103547. [Google Scholar] [CrossRef]
 - Islam, S.; Arnold, L.; Padhye, R. Comparison and characterisation of regenerated chitosan from 1-butyl-3-methylimidazolium chloride and chitosan from crab shells. BioMed Res. Int. 2015, 2015. [Google Scholar] [CrossRef]
 - Kozanoǧlu, S.; Özdemir, T.; Usanmaz, A. Polymerization of N-vinylcaprolactam and characterization of poly (N-vinylcaprolactam). J. Macromol. Sci. Part A 2011, 48, 467–477. [Google Scholar] [CrossRef]
 - Das, S.S.; Bharadwaj, P.; Bilal, M.; Barani, M.; Rahdar, A.; Taboada, P.; Bungau, S.; Kyzas, G.Z. Stimuli-responsive polymeric nanocarriers for drug delivery, imaging, and theragnosis. Polymers 2020, 12, 1397. [Google Scholar] [CrossRef]
 - Xie, Y.; Tuguntaev, R.G.; Mao, C.; Chen, H.; Tao, Y.; Wang, S.; Yang, B.; Guo, W. Stimuli-responsive polymeric nanomaterials for rheumatoid arthritis therapy. Biophys. Rep. 2020, 6, 193–210. [Google Scholar] [CrossRef]
 - Qian, Q.; Niu, S.; Williams, G.R.; Wu, J.; Zhang, X.; Zhu, L.-M. Peptide functionalized dual-responsive chitosan nanoparticles for controlled drug delivery to breast cancer cells. Colloids Surf. A Physicochem. Eng. Asp. 2019, 564, 122–130. [Google Scholar] [CrossRef]
 - Chen, X.; Song, L.; Li, X.; Zhang, L.; Li, L.; Zhang, X.; Wang, C. Co-delivery of hydrophilic/hydrophobic drugs by multifunctional yolk-shell nanoparticles for hepatocellular carcinoma theranostics. Chem. Eng. J. 2020, 389, 124416. [Google Scholar] [CrossRef]
 - Bruschi, M.L. Strategies to Modify the Drug Release from Pharmaceutical Systems; Woodhead Publishing: Sawston, UK, 2015. [Google Scholar]
 - Paul, D. Elaborations on the Higuchi model for drug delivery. Int. J. Pharm. 2011, 418, 13–17. [Google Scholar] [CrossRef]
 - Paarakh, M.P.; Jose, P.A.; Setty, C.; Christoper, G. Release kinetics–concepts and applications. Int. J. Pharm. Res. Technol. 2018, 8, 12–20. [Google Scholar]
 - Guo, X.; Zhuang, Q.; Ji, T.; Zhang, Y.; Li, C.; Wang, Y.; Li, H.; Jia, H.; Liu, Y.; Du, L. Multi-functionalized chitosan nanoparticles for enhanced chemotherapy in lung cancer. Carbohydr. Polym. 2018, 195, 311–320. [Google Scholar]
 - Al-Kinani, M.A.; Haider, A.J.; Al-Musawi, S. Design, construction and characterization of intelligence polymer coated core–shell nanocarrier for curcumin drug encapsulation and delivery in lung cancer therapy purposes. J. Inorg. Organomet. Polym. Mater. 2021, 31, 70–79. [Google Scholar] [CrossRef]
 - Shim, S.; Yoo, H.S. The application of mucoadhesive chitosan nanoparticles in nasal drug delivery. Mar. Drugs 2020, 18, 605. [Google Scholar] [CrossRef]
 - Mur, L.A.; Huws, S.A.; Cameron, S.J.; Lewis, P.D.; Lewis, K.E. Lung cancer: A new frontier for microbiome research and clinical translation. Ecancermedicalscience 2018, 12, 866. [Google Scholar] [CrossRef] [PubMed]
 - Demartis, S.; Obinu, A.; Gavini, E.; Giunchedi, P.; Rassu, G. Nanotechnology-based rose Bengal: A broad-spectrum biomedical tool. Dye. Pigment. 2021, 188, 109236. [Google Scholar] [CrossRef]
 - Ferreira, T.A.C.; Warth, J.F.G.; Dos Santos, L.L.; Moore, B.A.; Montiani-Ferreira, F. Antimicrobial activity of topical dyes used in clinical veterinary ophthalmology. Vet. Ophthalmol. 2020, 23, 497–505. [Google Scholar] [CrossRef] [PubMed]
 - Gottenbos, B.; Grijpma, D.W.; van der Mei, H.C.; Feijen, J.; Busscher, H.J. Antimicrobial effects of positively charged surfaces on adhering Gram-positive and Gram-negative bacteria. J. Antimicrob. Chemother. 2001, 48, 7–13. [Google Scholar] [CrossRef] [PubMed]
 - Gao, M.; Long, X.; Du, J.; Teng, M.; Zhang, W.; Wang, Y.; Wang, X.; Wang, Z.; Zhang, P.; Li, J. Enhanced curcumin solubility and antibacterial activity by encapsulation in PLGA oily core nanocapsules. Food Funct. 2020, 11, 448–455. [Google Scholar] [CrossRef]
 - Mahmud, M.M.; Zaman, S.; Perveen, A.; Jahan, R.A.; Islam, M.F.; Arafat, M.T. Controlled release of curcumin from electrospun fiber mats with antibacterial activity. J. Drug Deliv. Sci. Technol. 2020, 55, 101386. [Google Scholar] [CrossRef]
 - Dong, Y.; Yang, Y.; Wei, Y.; Gao, Y.; Jiang, W.; Wang, G.; Wang, D. Facile synthetic nano-curcumin encapsulated Bio-fabricated nanoparticles induces ROS-mediated apoptosis and migration blocking of human lung cancer cells. Process Biochem. 2020, 95, 91–98. [Google Scholar] [CrossRef]
 - Hoshikawa, A.; Nagira, M.; Tane, M.; Fukushige, K.; Tagami, T.; Ozeki, T. Preparation of curcumin-containing α-, β-, and γ-cyclodextrin/polyethyleneglycol-conjugated gold multifunctional nanoparticles and their in vitro cytotoxic effects on A549 cells. Biol. Pharm. Bull. 2018, 41, 908–914. [Google Scholar] [CrossRef]
 - Praveena, J.; Hakkimane, S.S.; Guru, B.R. Synergistic effect of Paclitaxel and Curcumin in nano-formulations on U87 and A549 cancer cell lines. J. Appl. Pharm. Sci. 2022, 12, 031–047. [Google Scholar]

| Formulation | Size (nm) | PDI | Zeta Potential (mV) | 
|---|---|---|---|
| Bare niosome | 41 ± 7 | 0.316 | −43.9 | 
| Curcumin-loaded niosome | 56 ± 15 | 0.327 | −46.1 | 
| Complete complex | 80 ± 13 | 0.364 | +30.7 | 
| Type of Drug | EE% | LC% | 
|---|---|---|
| Curcumin | 97.19% | 7.67% | 
| Rose Bengal | 98.21% | 8.61% | 
| Formulation/Model | Korsmayer–Peppas | Higuchi | Zero Order | First Order | Hixson–Crowell | |
|---|---|---|---|---|---|---|
| (RB/CUR) | (R2) | (n) | (R2) | (R2) | (R2) | (R2) | 
| RB1 | 0.9943 | 0.46 | 0.9615 | 0.8835 | 0.6018 | 0.7204 | 
| RB2 | 0.9806 | 0.48 | 0.9705 | 0.9148 | 0.6888 | 0.7816 | 
| RB3 | 0.9954 | 0.46 | 0.9806 | 0.8955 | 0.6581 | 0.7569 | 
| RB4 | 0.9730 | 0.47 | 0.9234 | 0.8685 | 0.6406 | 0.7306 | 
| CUR1 | 0.9962 | 0.49 | 0.9810 | 0.9032 | 0.6720 | 0.7683 | 
| CUR2 | 0.9962 | 0.47 | 0.9808 | 0.9053 | 0.6499 | 0.7537 | 
| CUR3 | 0.9954 | 0.46 | 0.9797 | 0.8970 | 0.6694 | 0.7635 | 
| CUR4 | 0.9858 | 0.5 | 0.9727 | 0.8909 | 0.6825 | 0.7650 | 
Disclaimer/Publisher’s Note: The statements, opinions and data contained in all publications are solely those of the individual author(s) and contributor(s) and not of MDPI and/or the editor(s). MDPI and/or the editor(s) disclaim responsibility for any injury to people or property resulting from any ideas, methods, instructions or products referred to in the content.  | 
© 2023 by the authors. Licensee MDPI, Basel, Switzerland. This article is an open access article distributed under the terms and conditions of the Creative Commons Attribution (CC BY) license (https://creativecommons.org/licenses/by/4.0/).
Share and Cite
Zarepour, A.; Egil, A.C.; Cokol Cakmak, M.; Esmaeili Rad, M.; Cetin, Y.; Aydinlik, S.; Ozaydin Ince, G.; Zarrabi, A. Fabrication of a Dual-Drug-Loaded Smart Niosome-g-Chitosan Polymeric Platform for Lung Cancer Treatment. Polymers 2023, 15, 298. https://doi.org/10.3390/polym15020298
Zarepour A, Egil AC, Cokol Cakmak M, Esmaeili Rad M, Cetin Y, Aydinlik S, Ozaydin Ince G, Zarrabi A. Fabrication of a Dual-Drug-Loaded Smart Niosome-g-Chitosan Polymeric Platform for Lung Cancer Treatment. Polymers. 2023; 15(2):298. https://doi.org/10.3390/polym15020298
Chicago/Turabian StyleZarepour, Atefeh, Abdurrahim Can Egil, Melike Cokol Cakmak, Monireh Esmaeili Rad, Yuksel Cetin, Seyma Aydinlik, Gozde Ozaydin Ince, and Ali Zarrabi. 2023. "Fabrication of a Dual-Drug-Loaded Smart Niosome-g-Chitosan Polymeric Platform for Lung Cancer Treatment" Polymers 15, no. 2: 298. https://doi.org/10.3390/polym15020298
APA StyleZarepour, A., Egil, A. C., Cokol Cakmak, M., Esmaeili Rad, M., Cetin, Y., Aydinlik, S., Ozaydin Ince, G., & Zarrabi, A. (2023). Fabrication of a Dual-Drug-Loaded Smart Niosome-g-Chitosan Polymeric Platform for Lung Cancer Treatment. Polymers, 15(2), 298. https://doi.org/10.3390/polym15020298
        
